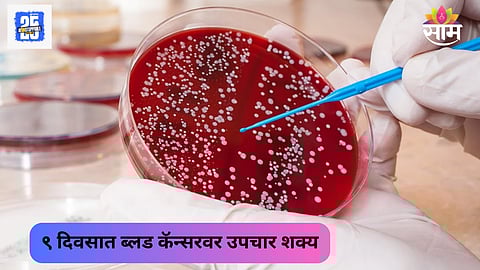

कॅन्सर हा शब्द जरी उच्चारला तरी अनेकांना धडकी भरते. मात्र जसं मेडिकल सायन्स विकसीत झालं आहे तसे यावर उपचार देखील शक्य झाले आहे. असंच नुकतंच भारतातील डॉक्टरांनी एक मोठी कामगिरी केली आहे. या डॉक्टरांच्या दाव्यानुसार, नऊ दिवसात ब्लड कॅन्सर नष्ट केला जाऊ शकतो.
ब्लड कॅन्सरवर हा महत्त्वाचा अभ्यास तामिळनाडूच्या क्रिश्चियन मेडिकल कॉलेज वेल्लोर आणि ICMR यांनी एकत्रितपणे केली आहे. या अभ्यासाचं नाव 'वेलकारटी' असं देण्यात आलं आहे. यामध्ये पहिल्यांदा CAR-T सेल्स ला रूग्णालयात बनवण्यात आलं आहे. माहितीनुसार, या टेस्टनंतर ८० टक्के लोकांमध्ये १५ महिन्यांपर्यंत कॅन्सर दिसून आला नाही.
इंडियन काऊंसिल ऑफ मेडिकल रिसर्च यांनी याबाबत माहिती दिली आहे. त्यांनी याला कॅन्सरच्या उपचांरामधील एक मोठं यश म्हटलंय. ICMR ने या ट्रायलबद्दल सांगताना म्हटलं की, कॅन्सरच्या उपचारांसाठी हा एक स्वस्त आणि वेगाने रिझल्ट देणारा पर्याय आहे.
ICMR आणि CMC वेल्लोर यांनी केलेल्या एका क्लिनिकल ट्रायलमध्ये या कॅन्सरवरील उपचारांना यश मिळाल्याचं सांगण्यात आलंय. ज्याला वेलकारटी नाव देण्यात आलं आहे. याचप्रमाणे भारत स्वदेशी बायो थेरेपी बनवण्यासाठी संपूर्ण जगात पुढे असल्याचं ICMR ने म्हटलंय.
हा अभ्यास मोलिक्यूलर थेरेपी ऑन्कोलॉजी जर्नलमध्ये पब्लिश करण्यात आला आहे. यानुसार, डॉक्टरांनी पहिल्यांदा CAR-T सेल्सला त्यांच्या रूग्णालयात बनवून ब्लड कॅन्सरच्या पेशंटवर टेस्ट केलं. यावेळी CAR-T थेरेपीच्या माध्यमातून एक्यूट लिम्फोब्लास्टिक ल्यूकेमिया (एएलएल) आणि लार्ज बी-सेल लिम्फोमा (एलबीसीएल)च्या रूग्णांवर टेस्ट केलं गेलं. या माध्यमातून रूग्णांना त्यांच्या टी-सेल्सला कॅन्सरविरूद्ध लढण्यासाठी तयार केलं गेलं.
भारतातील हा कार-टी थेरेपी पहिला अभ्यास नाहीये. यापूर्वी इम्यून एक्ट आणि टाटा मेमोरियर रूग्णालयाने मिळून यासंदर्भात एक अभ्यास केला होता. ज्यामध्ये पहिली स्वदेशी थेरेपी विकसीत केली गेली होती. ज्याला २०२३ मध्ये केंद्राने परवानगी दिली होती.
सकाळ+चे सदस्य व्हा
शॉपिंगसाठी 'सकाळ प्राईम डील्स'च्या भन्नाट ऑफर्स पाहण्यासाठी क्लिक करा.
Read Marathi news and watch Live TV. Breaking news from Maharashtra, India, Pune, Mumbai, Politics, Entertainment, Sports, Lifestyle at SaamTV. Get Live Marathi news on Mobile. Download the Saam Tv app for Android and IOS.